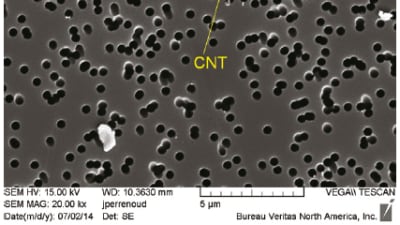
Feature Image

Latest Stories
Articles Aerospace
Rotorcraft Icing Computational Tool Development
The formation of ice over lifting surfaces can affect aerodynamic performance. In the case of helicopters, this loss in lift and the increase in sectional drag forces will have a dramatic effect...

Articles RF & Microwave Electronics
Curled RF MEMS Switches For On-Chip Design
Microelectromechanical system (MEMS) switches are active components in most electronic equipment. Radio frequency (RF) MEMS are used in wireless personal communication devices, satellite communication,...

Articles Defense
Design Software Supports BAE System’s Mixed-Signal Chip Design
BAE Systems is a global defense and aerospace company, delivering products and services for air, land, and naval forces, as well as electronics, information technology solutions,...

Product Briefs Software
Thermal Simulation Tool
CoTherm from ThermoAnalytics facilitates the flow of information between CAE simulation products to streamline CAE workflow, improve simulation time and reduce test time and cost. Instead of working with complicated...

News Manufacturing & Prototyping
Federal Lab Cost-Effectively Eliminates Diesel Idling to Condition Class 8 Sleeper Cabs
You see them at the side of roads, in parking lots and pull-off areas of highways—Class 8 over-the-road trucks with their diesel engines idling...

Articles Aerospace
Using SWaP-C Reductions to Improve UAS/UGV Mission Capabilities
The defense and aerospace market continues to push for reductions in size, weight, power, and cost (SWaP-C) to support advanced sensor/vetronics payloads onboard unmanned...

Articles Defense
Designing Rugged Computing Platforms for UGVs
While the military’s proliferation of unmanned aircraft, or drones, continues to grab the headlines, the deployment of unmanned ground vehicles (UGV) is also anticipated to expand based on their...

Articles Aerospace
Bi-manual Dexterous Manipulation for Maritime Explosive Ordnance Disposal
Since 2001, there has been a proliferation of robots within the U.S. military to assist with Explosive Ordnance Disposal (EOD) missions. Ground robotics systems are able...

Articles Aerospace
Designing a Robot to Counter Vehicle-Borne Improvised Explosive Devices
The use of Vehicle-Borne Improvised Explosive Devices (VBIED) has increased each year. Current anti-VBIED technology is not only expensive, but requires months or years of...

Articles Unmanned Systems
Applying UUV Advances to Safeguard Harbors and Littoral Waters
Advances in unmanned underwater vehicles (UUVs) are providing government agencies and commercial organizations with new capabilities across a variety of mission requirements....

Articles Materials
Managing the Impact of Nanomaterials in Aerospace Manufacturing
As the aerospace industry continues to make improvements to safety, comfort and affordability of aircraft, nanomaterials are making their way into more elements of aircraft...
Articles Manufacturing & Prototyping
Turbine Flow Meters: Technology-of-Choice for Measuring Critical Fluid Flow Applications
The aerospace industry has some of the most difficult operating conditions imaginable. Sensors of all kinds used in this industry must stand up to the...

Articles Aerospace
Designing a Power Generation System for a More-Electric Aircraft
It is theorized that systems and equipment for an All Electric Aircraft (AEA) will be developed 20 years hence as a More-Electric Aircraft (MEA) with no bleed system, which is a...

Articles Aerospace
XPONENTIAL: An AUVSI Experience
At AUVSI’s Unmanned Systems 2015 in Atlanta Georgia, it was announced that the conference and trade show was being officially rebranded in 2016 to XPONENTIAL – An AUVSI Experience. The event, which runs from...

Articles Sensors/Data Acquisition
Next Generation FPGAs for Electronic Warfare Systems
Designers of virtually all electronic warfare system applications exploit CPUs and FPGAs, each offering unique strengths and advantages for handling a wide range of tasks. This diversity...

Articles Aerospace
International Microwave Symposium Preview
The 2016 International Microwave Symposium (IMS2016), organized by the IEEE Microwave Theory and Technique Society (MTT-S), is the annual international meeting for technologists involved in all aspects...

Articles Data Acquisition
Developing an Auto-Synchronized Multi-Avionics Protocol Data Bus Acquisition System
A modern aircraft includes multiple intelligent subsystems that aid in communication, navigation, and surveillance. These subsystems, called line replaceable...

News Propulsion
Stricter Stage V Regs Pose Challenges
Worried about the adverse health effects of diesel exhaust in general, and diesel soot in particular, the European Commission’s new Stage V regulations will further reduce allowable limits on criteria...

Articles Sensors/Data Acquisition
Optimizing Thermal Management to Meet SWaP-C Requirements
As defense systems continue to shrink, corresponding thermal management concerns expand exponentially. Designers have learned that overheating can be the downfall of even the most...

Articles Defense
Fighting for Life in Military Markets
Visits to the Seville headquarters of Airbus Defence & Space (Airbus DS) have often reflected stormy prospects for the company’s large-capacity A400M Atlas transport, which has suffered cost...

Articles Aerospace
Clamoring for More Entertainment
Consumer expectations for information and entertainment are creating big challenges for airlines that need to provide Internet access while providing inflight services that mirror what’s available in the home...

Articles Defense
Cellular Satellites: Joint Communications with Integrated Acquisition
It’s a familiar image: a soldier crouching with a radio next to a spidery antenna pointing skyward to reach a distant satellite. But that view of military communications is...

Articles Aerospace
DPA Countermeasures — Theory vs. Practice
The Threat In today’s interconnected world, the information that we generate, store, transmit, and receive has become a valuable commodity. We have increasingly turned to cryptography as a tool to...

Articles Aerospace
A Hardware-Centric Approach to Countering Side-Channel Threats
From laptops and mobile devices to cars and airplanes, we are seeing near-daily threats to the systems and devices we use. Systems being used and deployed in the aerospace and...

Articles Aerospace
Virtual Flight Testing of Radar System Performance
Flight testing is the ultimate way to evaluate the performance of a radar system. During the actual aircraft flight, data such as Probability of Detection, Signal Strength, and clutter might be...

News Electronics & Computers
HMIs Offer Something for Everyone
Equipment buyers typically focus on factors like horsepower and lifting capability, but human-machine interfaces may be the most important factor for off-highway vehicle operators. Differentiating these...

News Power
Hybrid Variety in Off-Highway
Perhaps the most interesting point about hybrids in the off-highway market is the sheer variety of architectures and energy storage choices.

Articles Energy
Electrified Off-Highway Powertrains Search for Marketing Power
Electrified powertrains have seen success in commercial applications like buses and small vehicles, but in many fields, they’ve seen only limited success. Today’s low fuel...

Articles Software
Tech Mahindra Buys Controlling Stake in Pininfarina
Tech Mahindra Ltd. and Mahindra & Mahindra (M&M) have jointly entered into an agreement with Pincar S.r.l. to purchase a controlling stake in Pininfarina S.p.A., an Italian brand...

Top Stories
NewsRF & Microwave Electronics
![]() Microvision Aquires Luminar, Plans Relationship Restoration, Multi-industry Push
Microvision Aquires Luminar, Plans Relationship Restoration, Multi-industry Push
INSIDERAerospace
![]() A Next Generation Helmet System for Navy Pilots
A Next Generation Helmet System for Navy Pilots
INSIDERDesign
![]() New Raytheon and Lockheed Martin Agreements Expand Missile Defense Production
New Raytheon and Lockheed Martin Agreements Expand Missile Defense Production
INSIDERMaterials
![]() How Airbus is Using w-DED to 3D Print Larger Titanium Airplane Parts
How Airbus is Using w-DED to 3D Print Larger Titanium Airplane Parts
NewsPower
![]() Ford Announces 48-Volt Architecture for Future Electric Truck
Ford Announces 48-Volt Architecture for Future Electric Truck
ArticlesAR/AI
Webcasts
Electronics & Computers
![]() Cooling a New Generation of Aerospace and Defense Embedded...
Cooling a New Generation of Aerospace and Defense Embedded...
Automotive
![]() Battery Abuse Testing: Pushing to Failure
Battery Abuse Testing: Pushing to Failure
Power
![]() A FREE Two-Day Event Dedicated to Connected Mobility
A FREE Two-Day Event Dedicated to Connected Mobility
Unmanned Systems
![]() Quiet, Please: NVH Improvement Opportunities in the Early Design Cycle
Quiet, Please: NVH Improvement Opportunities in the Early Design Cycle
Automotive
![]() Advantages of Smart Power Distribution Unit Design for Automotive &...
Advantages of Smart Power Distribution Unit Design for Automotive &...
Energy
![]() Sesame Solar's Nanogrid Tech Promises Major Gains in Drone Endurance
Sesame Solar's Nanogrid Tech Promises Major Gains in Drone Endurance




